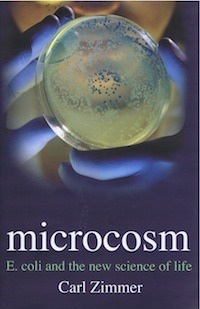

Carl Zimmer's Blog, page 63
June 3, 2011
Arsenic life creates a new blogger: Please welcome Steven Benner!
 During the whole arsenic life kerfuffle, chemist Steven Benner expressed his skepticism early and often. He wrote one of the eight critiques that Science posted last week, six months after the initial paper.
During the whole arsenic life kerfuffle, chemist Steven Benner expressed his skepticism early and often. He wrote one of the eight critiques that Science posted last week, six months after the initial paper.
Last night Benner sent me an email:
Carl:
I have now blogged on this, since the cycle of publication at Science is rather slow.
Steve
To which I can only say: Heh. And, Read it!
May 31, 2011
The chronic fatigue virus: de-discovered?
One of the most important things that virus-hunters do is "de-discover" links between viruses and diseases. In other words, they follow up on studies that indicate a link and see if it can really hold up. Last year, a team of scientists published a paper in Science in which they reported that 67% of people they studied who suffer from chronic fatigue syndrome carried a virus in their system known as XMRV. Only 3.7% of healthy people did. That association then morphed into the idea that XMRV actually causes chronic fatigue (a condition that afflicts an estimated 60 million people worldwide). Some people with chronic fatigue have sought anti-viral medicines based on the finding, declaring that they've felt better as a result. But when a lot of other scientists tried to find XMRV, they failed to do so.
Today Science itself is publishing two papers that cast even more doubt on the link. In one study, scientists looked at 61 samples from the same medical practice where the original samples had come from. They couldn't find any XMRV in people with chronic fatigue.
Another study supports what a lot of experts have been saying recently: that XMRV was not ...

May 28, 2011
Lisa Randall to judge this year's 3 Quarks Daily science prize. Send in your nomination!
 The blog 3 Quarks Daily awards an annual prize for the best science blog post of the year. This year, Harvard physicist Lisa Randall is judging the entries. The deadline is May 21, 11:59 pm EST. If there's a blog post that has really stood out in your memory from the past year (since May 22, 2010 to be precise), go here to nominate it.
The blog 3 Quarks Daily awards an annual prize for the best science blog post of the year. This year, Harvard physicist Lisa Randall is judging the entries. The deadline is May 21, 11:59 pm EST. If there's a blog post that has really stood out in your memory from the past year (since May 22, 2010 to be precise), go here to nominate it.

The Symmetry of Sleep
 The World Science Festival is going to kick off on Wednesday in New York (I'll be speaking Thursday on a panel, on telling the stories of science in print and online.) The festival organizers have been publishing a blog on some of the topics that will be explored next week. Riffing on the session on sleep, I've just contributed a piece on some wonderful recent research on what it means for us to be asleep and to be awake–and the surprising porous wall that divides the two states of mind. Check it out.
The World Science Festival is going to kick off on Wednesday in New York (I'll be speaking Thursday on a panel, on telling the stories of science in print and online.) The festival organizers have been publishing a blog on some of the topics that will be explored next week. Riffing on the session on sleep, I've just contributed a piece on some wonderful recent research on what it means for us to be asleep and to be awake–and the surprising porous wall that divides the two states of mind. Check it out.
[ Image: Wikipedia ]
May 27, 2011
Arsenic life redux: how #arseniclife helped change science
It's been six months since #arseniclife became one of my favorite hashtags on Twitter. Over at Slate, I look at how the online conversation has changed the way scientists do their work. Check it out.

Engineering the planet–with viruses?
Today I close out a month-long guest blog over at the University of Chicago Press to mark the publication of my book A Planet of Viruses. I've been talking with experts about some of the most thought-provoking areas of virus research–
1. Can viruses control our minds?
2. Should we eliminate smallpox?
3. How can we use viruses to cure disease?
Today I talk with Penny Chisholm of MIT about the viruses that fill the worlds oceans (a billion in every spoonful). They kill off half the bacteria in the ocean every day, dumping out carbon and having enormous ecological effects–and perhaps even effects on the planet's climate. Chisholm and I speculate on whether we could use viruses to manipulate the planet as a whole. It's extreme speculation to be sure–but, then again, when it comes to viruses, the truth can sometimes seem too fantastic to be real. Check it out!
May 24, 2011
Another purge sale: autographed copies of the UK hardback edition of Microcosm
Last week I announced that I had 17 autographed copies of the US hardback edition of Microcosm, and in 85 minutes you folks cleared me out. There were a few cries of "Arg!" later on Facebook and Twitter, to which I responded that I still needed to deal with more books in advance of our house renovation. And so (voice turning crazy), here's the next deal: we've got 8 autographed copies of the British hardback edition of Microcosm: E. coli and the New Science of Life. It's out of print, but between now and next Tuesday, it's available for ten dollars from my Amazon store.
Last week I announced that I had 17 autographed copies of the US hardback edition of Microcosm, and in 85 minutes you folks cleared me out. There were a few cries of "Arg!" later on Facebook and Twitter, to which I responded that I still needed to deal with more books in advance of our house renovation. And so (voice turning crazy), here's the next deal: we've got 8 autographed copies of the British hardback edition of Microcosm: E. coli and the New Science of Life. It's out of print, but between now and next Tuesday, it's available for ten dollars from my Amazon store.
Again, here's a quick description of Microcosm: In the book, I tilt at one of my favorite windmills–the definition of life. But rather than try to take on all of life on Earth, I chose one species–the one that we know best of all. That would be our gastrointestinal lodger, Escherichia coli, the little bug that helped build modern biology and launch the entire biotechnology industry. In my biography of this scrutinized germ, I explore the origin of life, our inner ecology, and ...

May 23, 2011
How a zombie virus became a big biotech business
 Sometimes a blog must serve as a repository of regrets, a place to atone for not including some perfect fact in a book. While working on my book Parasite Rex, I came across many delicious examples of parasites manipulating the behavior of their hosts for their own benefit. After the book came out, I met scientists who enlightened me about other examples which would have been wonderful to include. A few years back, for example, a Johns Hopkins scientist pointed me to a parasitic wasp that turns cockroaches into zombies.
Sometimes a blog must serve as a repository of regrets, a place to atone for not including some perfect fact in a book. While working on my book Parasite Rex, I came across many delicious examples of parasites manipulating the behavior of their hosts for their own benefit. After the book came out, I met scientists who enlightened me about other examples which would have been wonderful to include. A few years back, for example, a Johns Hopkins scientist pointed me to a parasitic wasp that turns cockroaches into zombies.
I've recently been wondering about behavior-altering viruses, thanks to an online conversation I had with Ian Lipkin, a virus hunter at Columbia University, about my new book A Planet of Viruses. Lipkin wondered aloud if some viruses would turn out to manipulate their hosts for their own good. Did herpesviruses, for example, increase its transmission by boosting their host's sexual desire?
Most of the examples I knew about came from parasitic animals and fungi. The only virus that could have this kind of effect that I knew of was rabies, which causes its hosts to become more ...
May 20, 2011
Eaters of bacteria: Is phage therapy ready for the big time?
Viruses that infect bacteria–known as bacteriophages–are the most abundant living things on Earth. (Yeah, that's right. I called viruses living things. You gotta problem with that?) For nearly a century, doctors and scientists have dreamed of using them as medical weapons against the microbes that make us sick. Over at the University of Chicago Press's blog, I discuss the enduring dream of phage therapy with MIT phage engineer Tim Lu, whom I profiled last year for Technology Review. This is my third UCP blog post to celebrate the publication of A Planet of Viruses; the next and last will appear next Friday.

May 19, 2011
We purge, you save! Get an autographed hardcover copy of Microcosm
 As I wrote on Monday, we're boxing up books in preparation for some house renovations. You were kind enough to take 21 autographed paperback copies of At the Water's Edge off our hands–in about three hours.
As I wrote on Monday, we're boxing up books in preparation for some house renovations. You were kind enough to take 21 autographed paperback copies of At the Water's Edge off our hands–in about three hours.
Well, we have even more books that we'd rather sell than pack.
Here's our new deal: we've got 17 autographed copies of the American hardback edition of Microcosm: E. coli and the New Science of Life. The hardback edition is out of print, but between now and next Thursday, you can buy them for the low, low price of ten dollars from my Amazon store. (Cue Crazy Eddie again!)
In Microcosm, I tilt at one of my favorite windmills: the definition of life. But rather than try to take on all of life on Earth, I chose one species–the one that we know best of all. That would be our gastrointestinal lodger, Escherichia coli, the little bug that helped build modern biology and launch the entire biotechnology industry. In my biography of this scrutinized germ, I explore the origin of life, our inner ecology, and the search for life on other planets. You ...
















